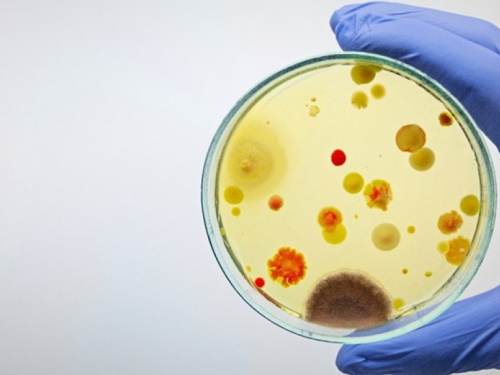

Određene bolesti koje se prenose sa životinja na ljude mogle bi ubiti 12 puta više ljudi 2050. godine nego 2020. godine, tvrde znanstvenici.
Stručnjaci iz američke biotehnološke tvrtke Ginkgo Bioworks pozvali su na "hitnu akciju" za smanjivanje rizika za globalno javno zdravlje. Epidemije uzrokovane zoonotskim bolestima mogle bi biti češće u budućnosti zbog klimatskih promjena i krčenja šuma, upozorili su.
Povijesni trendovi četiri virusna patogena
Analiza je promatrala povijesne trendove za četiri određena virusna patogena. Radilo se o filovirusima, koji uključuju virus ebole i virus Marburg, SARS Coronavirus 1, virus Nipah i virus machupo, koji uzrokuje bolivijsku hemoragičnu groznicu.
Studija nije uključila covid-19, koji je izazvao globalnu pandemiju 2020. godine i vjerojatno potječe od šišmiša. Znanstvenici su pregledali više od 3150 izbijanja između 1963. i 2019., identificirajući 75 prijenosa sa životinja na ljude u 24 zemlje.
Baza podataka pokrivala je epidemije o kojima je izvijestila Svjetska zdravstvena organizacija (WHO), izbijanja koja su se dogodila od 1963. godine i koja su ubila 50 ili više ljudi te povijesno značajne događaje uključujući pandemije gripe 1918. i 1957. godine.
"Potrebna je hitna akcija za rješavanje velikog i rastućeg rizika za globalno zdravlje"
Događaji su prouzročili 17.232 smrti, od kojih je 15.771 uzrokovano filovirusima i uglavnom se dogodilo u Africi.
Znanstvenici su rekli da su se epidemije povećavale za gotovo 5 posto svake godine između 1963. i 2019., a smrtnost je porasla za 9 posto. "Ako se ove godišnje stope porasta nastave, očekujemo da će analizirani patogeni uzrokovati četiri puta veći broj prijenosa i 12 puta veći broj smrtnih slučajeva 2050. nego 2020.", dodali su.
Oni su također sugerirali da su brojke vjerojatno podcijenjene zbog strogih kriterija uključivanja patogena u analizu i isključivanja covida-19. Rekli su da procjena dokaza sugerira da nedavne epidemije izazvane prelijevanjem zoonoza "nisu aberacija ili slučajnost" već slijede "višedesetljetni trend u kojem su epidemije izazvane prelijevanjem postale veće i učestalije".
Tim je dodao da je "potrebna hitna akcija za rješavanje velikog i rastućeg rizika za globalno zdravlje" na temelju povijesnih trendova. Nalazi studije objavljeni su u časopisu BMJ Global Health.
Stručnjaci iz američke biotehnološke tvrtke Ginkgo Bioworks pozvali su na "hitnu akciju" za smanjivanje rizika za globalno javno zdravlje. Epidemije uzrokovane zoonotskim bolestima mogle bi biti češće u budućnosti zbog klimatskih promjena i krčenja šuma, upozorili su.
Povijesni trendovi četiri virusna patogena
Analiza je promatrala povijesne trendove za četiri određena virusna patogena. Radilo se o filovirusima, koji uključuju virus ebole i virus Marburg, SARS Coronavirus 1, virus Nipah i virus machupo, koji uzrokuje bolivijsku hemoragičnu groznicu.
Studija nije uključila covid-19, koji je izazvao globalnu pandemiju 2020. godine i vjerojatno potječe od šišmiša. Znanstvenici su pregledali više od 3150 izbijanja između 1963. i 2019., identificirajući 75 prijenosa sa životinja na ljude u 24 zemlje.
Baza podataka pokrivala je epidemije o kojima je izvijestila Svjetska zdravstvena organizacija (WHO), izbijanja koja su se dogodila od 1963. godine i koja su ubila 50 ili više ljudi te povijesno značajne događaje uključujući pandemije gripe 1918. i 1957. godine.
"Potrebna je hitna akcija za rješavanje velikog i rastućeg rizika za globalno zdravlje"
Događaji su prouzročili 17.232 smrti, od kojih je 15.771 uzrokovano filovirusima i uglavnom se dogodilo u Africi.
Znanstvenici su rekli da su se epidemije povećavale za gotovo 5 posto svake godine između 1963. i 2019., a smrtnost je porasla za 9 posto. "Ako se ove godišnje stope porasta nastave, očekujemo da će analizirani patogeni uzrokovati četiri puta veći broj prijenosa i 12 puta veći broj smrtnih slučajeva 2050. nego 2020.", dodali su.
Oni su također sugerirali da su brojke vjerojatno podcijenjene zbog strogih kriterija uključivanja patogena u analizu i isključivanja covida-19. Rekli su da procjena dokaza sugerira da nedavne epidemije izazvane prelijevanjem zoonoza "nisu aberacija ili slučajnost" već slijede "višedesetljetni trend u kojem su epidemije izazvane prelijevanjem postale veće i učestalije".
Tim je dodao da je "potrebna hitna akcija za rješavanje velikog i rastućeg rizika za globalno zdravlje" na temelju povijesnih trendova. Nalazi studije objavljeni su u časopisu BMJ Global Health.